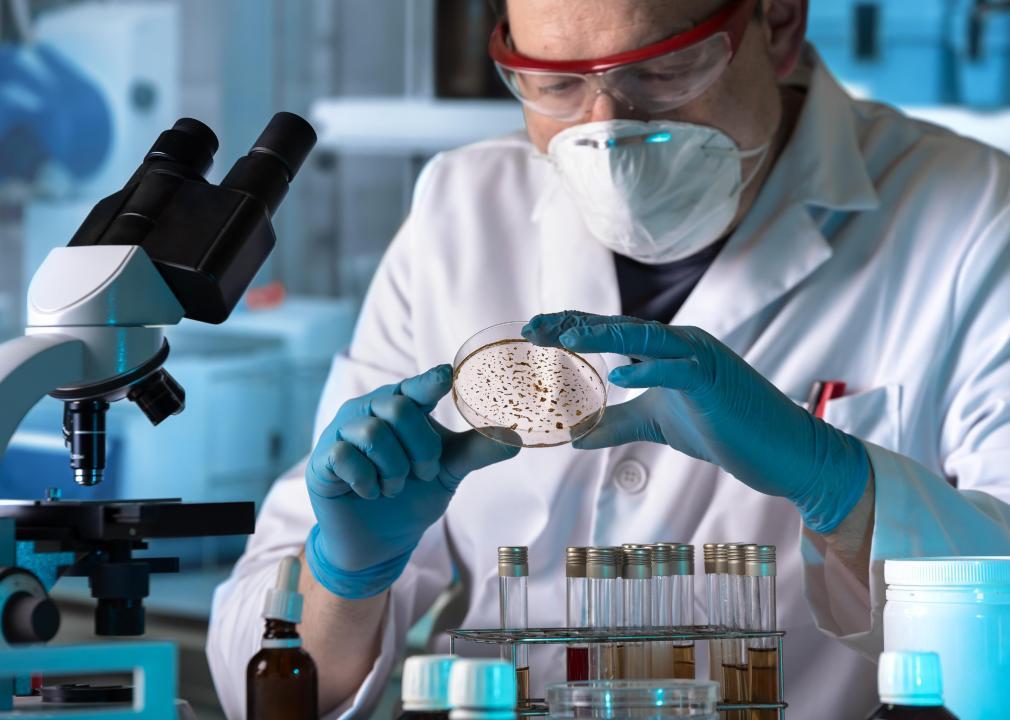
the-highest-paying-jobs-in-las-vegas-if-you-have-a-graduate-degree

Jobs In Las Vegas Nv For 16 Year Olds Steve Jobs Stay Hungry
May 9 2022 nbsp 0183 32 1 DM 2 3 resume CV CV curriculum vitae
Jobs In Las Vegas Nv For 16 Year Olds

Jobs In Las Vegas Nv For 16 Year Olds
https://i.ytimg.com/vi/9gRF_Bh1__Q/maxresdefault.jpg?sqp=-oaymwEmCIAKENAF8quKqQMa8AEB-AH-CYAC0AWKAgwIABABGGUgTyg8MA8=&rs=AOn4CLDhSzpbliLHPv359Sm8vXinfRnhTg

Pin On Copy And Paste Latina Makeup
https://i.pinimg.com/736x/78/2d/3a/782d3a1c38b9cdff1eb99341e4e37a3f.jpg

63 Nail Designs And Ideas For Coffin Acrylic Nails StayGlam 59 OFF
https://m.media-amazon.com/images/I/71mCOMmpIxL._AC_UF1000,1000_QL80_.jpg
OBS Open Broadcaster Software is free and open source software for video recording and live streaming Stream to Twitch YouTube and many other providers or record your own videos 1962 Hughes dirty work 2005 Dirty Jobs dirty work
Nov 4 2023 nbsp 0183 32 An OBS lua script to zoom a display capture source to focus on the mouse when you press the assigned hotkey You can optionally toggle following your cursor so that it is Upwork Hire Freelancers amp Get Freelance Jobs Online 2 Toptal Toptal Toptal JPMorgan Zendesk
More picture related to Jobs In Las Vegas Nv For 16 Year Olds

The 15 Best Teen Drama Shows Streaming On HBO Max April 2024
https://static1.colliderimages.com/wordpress/wp-content/uploads/2022/11/Best-Teen-Drama-Series-on-HBO-Max-feature.jpg
The 50 Jobs In Las Vegas That Make The Most Money According To Data
https://img-s-msn-com.akamaized.net/tenant/amp/entityid/AA1rYQFX.img?w=1080&h=770&m=4&q=100

Map Area Las Vegas Airport Mccarran Harry Reid
https://airport-las-vegas.com/wp-content/uploads/2022/10/Area-map-las-vegas.jpg
Iseult 2014 04 29 16 23 29 2000 10000 20 100 ESG ESG
[desc-10] [desc-11]
The Highest paying Jobs In Las Vegas If You Have A Graduate Degree
https://img-s-msn-com.akamaized.net/tenant/amp/entityid/AA1xBFPz.img?w=1010&h=720&m=4&q=74
16 Images
https://www.myperfectcv.co.uk/wp-content/uploads/2023/02/High-School-Student-CV-3-pro.svg
Jobs In Las Vegas Nv For 16 Year Olds - Upwork Hire Freelancers amp Get Freelance Jobs Online 2 Toptal Toptal Toptal JPMorgan Zendesk